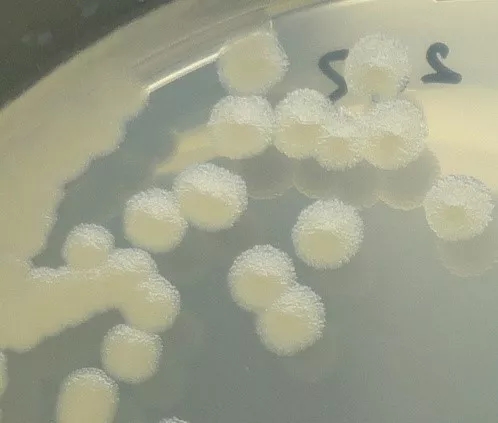

近期,很多人问“炭疽是什么病?”“炭疽可怕吗?”“炭疽可以人传人吗?”“牛羊肉还能不能吃?”等问题。
下面我们一起来了解一下有关炭疽的知识~
01
炭疽是什么?
炭疽,是一种叫做炭疽芽胞杆菌的细菌引起的人兽共患性传染病,主要发生在牛马羊等草食动物中,人通常是通过接触患病动物或动物制品被感染。我国的炭疽多发生在西部地区,以农、牧民为多。
炭疽芽胞杆菌在普通培养基上的菌落形态 本文图片均来自“中国疾控动态”微信公众号
高倍显微镜下的杆状菌体及芽胞
2
炭疽可怕吗?
我们一般说的炭疽是指由人类接触病死动物及其制品而感染的疾病,是一种比较常见的传染病,以皮肤炭疽为主,只要早发现、早诊断、早治疗,治愈率很高,预后很好,一般不留后遗症且很少有死亡病例,所以炭疽并不可怕。
3、人是怎么感染上炭疽的?
大多数情况下,总是牛马羊等食草动物在吃草时摄入芽胞引起感染,患病动物的血液、粪尿排泄物、乳汁,病死畜的内脏、骨骼等可含有大量的炭疽芽胞杆菌,人在宰杀、剥食病患动物时,或者接触了可能被病患动物的血液、排泄物等污染过的物品时,该细菌便可能通过皮肤上的微小伤口进入体内,引起感染,这也是最常见的皮肤炭疽类型,占全部病例的95%以上。
炭疽还可以经口感染,主要是摄入了含有该菌的污染食物引起的肠炭疽,这多与饮食习惯和食品加工有关,如未经任何处理的风干牛肉等。炭疽还可因吸入污染有炭疽芽胞的尘埃和气溶胶,引起肺炭疽,这种感染很少见,最常在皮毛加工厂的工人中发生。
4、炭疽有什么症状?
皮肤炭疽病变多见于面、颈、肩、手和脚等裸露部位皮肤;主要表现为局部皮肤的水肿、斑疹或丘疹、水疱、溃疡和焦痂;疼痛不明显,稍有痒感,无脓肿形成。及时治疗病死率小于1%。
肠炭疽可表现为急性肠炎型或急腹症型。急性肠炎型发病时可出现恶心呕吐、腹痛、腹泻。急腹症型患者全身中毒症状严重,持续性呕吐及腹泻,排血水样便,腹胀、腹痛,常并发败血症和感染性休克。如不及时治疗,常可导致死亡。
肺炭疽初起为“流感样”症状,表现为低烧,疲乏,全身不适,肌痛,咳嗽,通常持续48小时左右。然后突然发展成一种急性病症,出现呼吸窘迫、气急喘鸣、咳嗽、紫绀、咯血等。可迅速出现昏迷和死亡,死亡率可达90%以上。
5、怎样预防炭疽?
最重要的一点就是不接触传染源。
炭疽的传染源主要是病死动物,发现牛、羊等动物生病或突然死亡,不接触、不宰杀、不食用、不买卖,立即报告当地农业畜牧部门,由该部门进行处理。
一旦发现自己或周围有人出现炭疽的症状,应立即报告当地卫生院或疾病预防控制机构,并及时就医。
注意从正规渠道购买牛羊肉制品,病死牛、羊肉以及来源不明的肉制品不能食用,烹饪时煮熟煮透可放心食用。
6、炭疽可以治疗吗?
炭疽是可以治疗的,作为一种细菌性传染病,使用抗生素治疗自然是首要要求。青霉素依然是治疗的首选药物,在大多数情况下,炭疽芽胞杆菌对青霉素没有抗药性。还有多种广谱抗生素对炭疽的治疗有效,可根据具体情况选用。皮肤炭疽的治疗不难,除了使用抗生素外,只需要简单的创面处理措施。其他类型的炭疽病情一般复杂并且较重,需要根据具体情况对症治疗。炭疽到了晚期,特别是出现全身出血症候的时候,确实很难救治。
因此炭疽病人治疗的关键在于早发现、早诊断、早治疗,任何延误都可能导致严重后果。
(来源:传染病所 张慧娟)
原标题:炭疽可怕吗?
下面我们一起来了解一下有关炭疽的知识~
01
炭疽是什么?
炭疽,是一种叫做炭疽芽胞杆菌的细菌引起的人兽共患性传染病,主要发生在牛马羊等草食动物中,人通常是通过接触患病动物或动物制品被感染。我国的炭疽多发生在西部地区,以农、牧民为多。
炭疽芽胞杆菌在普通培养基上的菌落形态 本文图片均来自“中国疾控动态”微信公众号
高倍显微镜下的杆状菌体及芽胞
2
炭疽可怕吗?
我们一般说的炭疽是指由人类接触病死动物及其制品而感染的疾病,是一种比较常见的传染病,以皮肤炭疽为主,只要早发现、早诊断、早治疗,治愈率很高,预后很好,一般不留后遗症且很少有死亡病例,所以炭疽并不可怕。
3、人是怎么感染上炭疽的?
大多数情况下,总是牛马羊等食草动物在吃草时摄入芽胞引起感染,患病动物的血液、粪尿排泄物、乳汁,病死畜的内脏、骨骼等可含有大量的炭疽芽胞杆菌,人在宰杀、剥食病患动物时,或者接触了可能被病患动物的血液、排泄物等污染过的物品时,该细菌便可能通过皮肤上的微小伤口进入体内,引起感染,这也是最常见的皮肤炭疽类型,占全部病例的95%以上。
炭疽还可以经口感染,主要是摄入了含有该菌的污染食物引起的肠炭疽,这多与饮食习惯和食品加工有关,如未经任何处理的风干牛肉等。炭疽还可因吸入污染有炭疽芽胞的尘埃和气溶胶,引起肺炭疽,这种感染很少见,最常在皮毛加工厂的工人中发生。
4、炭疽有什么症状?
皮肤炭疽病变多见于面、颈、肩、手和脚等裸露部位皮肤;主要表现为局部皮肤的水肿、斑疹或丘疹、水疱、溃疡和焦痂;疼痛不明显,稍有痒感,无脓肿形成。及时治疗病死率小于1%。
肠炭疽可表现为急性肠炎型或急腹症型。急性肠炎型发病时可出现恶心呕吐、腹痛、腹泻。急腹症型患者全身中毒症状严重,持续性呕吐及腹泻,排血水样便,腹胀、腹痛,常并发败血症和感染性休克。如不及时治疗,常可导致死亡。
肺炭疽初起为“流感样”症状,表现为低烧,疲乏,全身不适,肌痛,咳嗽,通常持续48小时左右。然后突然发展成一种急性病症,出现呼吸窘迫、气急喘鸣、咳嗽、紫绀、咯血等。可迅速出现昏迷和死亡,死亡率可达90%以上。
5、怎样预防炭疽?
最重要的一点就是不接触传染源。
炭疽的传染源主要是病死动物,发现牛、羊等动物生病或突然死亡,不接触、不宰杀、不食用、不买卖,立即报告当地农业畜牧部门,由该部门进行处理。
一旦发现自己或周围有人出现炭疽的症状,应立即报告当地卫生院或疾病预防控制机构,并及时就医。
注意从正规渠道购买牛羊肉制品,病死牛、羊肉以及来源不明的肉制品不能食用,烹饪时煮熟煮透可放心食用。
6、炭疽可以治疗吗?
炭疽是可以治疗的,作为一种细菌性传染病,使用抗生素治疗自然是首要要求。青霉素依然是治疗的首选药物,在大多数情况下,炭疽芽胞杆菌对青霉素没有抗药性。还有多种广谱抗生素对炭疽的治疗有效,可根据具体情况选用。皮肤炭疽的治疗不难,除了使用抗生素外,只需要简单的创面处理措施。其他类型的炭疽病情一般复杂并且较重,需要根据具体情况对症治疗。炭疽到了晚期,特别是出现全身出血症候的时候,确实很难救治。
因此炭疽病人治疗的关键在于早发现、早诊断、早治疗,任何延误都可能导致严重后果。
(来源:传染病所 张慧娟)
原标题:炭疽可怕吗?
本文地址:https://www.24fa.com/n58569c87.aspx,转载请注明24FA出处。